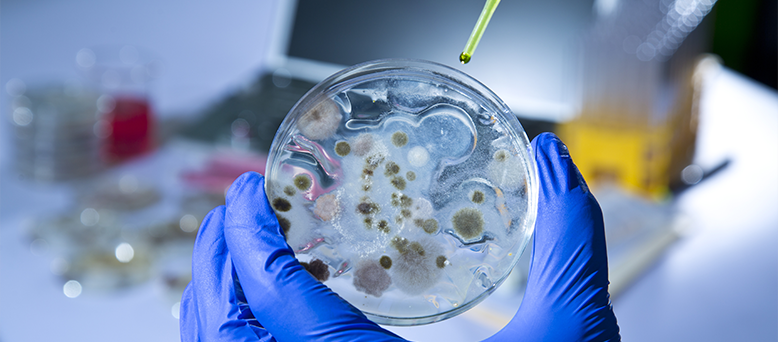

Technology
FOLLOW US ON


Used throughout the vent systems to see if there is any evidence of visual mold growth throughout the vents (which if you’re having a smell, it’s very possible that that’s what you’re smelling since if there is mold in the vents, every time you run the central A/C unit it is cross contaminating).

Used to detect moisture and water damage/condensation present behind walls, ceilings, and floors.

Used to detect and measure moisture and water damage/condensation present behind walls, ceilings, and floors.

Used to see if there are any “cool spots” that might be contributing to any mold growth which is common around the central A/C units and windows.

Used to detect and measure moisture levels present behind wall(s) and ceiling(s).

Used to detect and measure humidity levels in area(s) of a property.

Used to verify if there are elevated levels of particles, dust and/or pollution present in the air throughout a property.

Used to measure the airflow from the central A/C unit(s), vent system(s) and/or ductwork.

Used to measure the temperature as well as airflow from vent system(s).

Used to measure humidity as well as active leak(s) inside wall(s), ceiling(s) and floor(s).

Used to find living organisms as well as particles on surfaces as well as on central A/C unit(s), vent system(s), ductwork, clothing, etc.

Deodorizers come in many forms. Thermal flogging is a comprehensive and multi-pronged process for HVAC mold remediation in which a deodorizer is heated and sprayed. Even the toughest to reach spots are not safe from the deodorizer. Miami Mold Specialist uses an exclusive AirBiotics cleaning solution that is:
- 100 percent organic
- free of volatile organic compounds
- eco-friendly
Miami Mold Specialist uses the state-of-the-art exclusive Carryall ULV Particle Fogger that combats even the smallest of particles found in hard to reach areas such as central A/C units, vents, attics and crawlspaces.
The fogger comes with features that allow us to work more efficiently, including
- a precision valve on the nozzle to adjust flow rate and particle size
- a flex hose to directly spray into narrow spaces and around corners

Minute particles on contaminated surfaces, such as in central A/C units, vents, attics and crawlspaces, are no match for Miami Mold Specialist’s Carryall ULV Particle Fogger. When performing a disinfection, we use our proprietary AirBiotics cleaning solution that is 100 percent organic and contains zero volatile organic compounds.
A precision valve on the nozzle adjusts the flow rate to particle size. Narrow spaces and corners are thoroughly cleaned via the flex hose spray.

High Efficiency Particulate Air, or HEPA, filters have been manufactured, tested, certified, and labeled in accordance with current HEPA filter standards. They have the ability to remove 99.97 percent of dust, pollen, mold, bacteria and any other airborne particles as small as 0.3 microns in diameter. The ultra-fine glass-fiber medium captures microscopic particles other filters may not detect via a combination of diffusion, interception and inertial impaction.
In addition to HEPA filters, an air scrubber is employed to restore air quality and remove airborne contaminants. This portable filtration system removes particles, gasses and/or chemicals from the air within a given area.
Using negative air pressurization, an air scrubber draws air in from the surrounding environment and passes it through a series of filters to remove contaminants. Airborne contaminants, such as mold, are trapped inside and filtered through a hose that leads to the outside of the property.
The air is reset 60-120 times during the span of the remediation service.

Mold can infest a property and damage personal items. If your business handles fine art, antiques, artifacts, collectibles, or other sensitive items, a low-risk CO2 decontamination room should be able to remove mold and offer up to one year of protection.
As the only one of its kind in North America, our CO2 decontamination chamber harnesses the power of a sealed room that is completely filled with CO2 and other natural cleaning solutions to decontaminate, sterilize, and remove mold from rare and expensive items, materials, collectibles, fabrics, and clothing.

After decades of experience in mold remediation, Miami Mold Specialist is proud to employ state-of-the-art Electrostatic Disinfecting Technology – the most effective sanitation method – that provides thorough cleaning of mold contaminated surfaces with exclusive precision.
Our Electrostatic Sprayers and certified technicians harness the power of electrostatic technology to produce the highest spray transfer efficiency possible by disinfecting a full 360-degree target area.
Benefits:
- Sanitizing
- Disinfecting
- Odor control
- Significantly reduced chemical exposure
- 75 percent more effective than other sprayers
- Eco-friendly
How it works:
A tiny electrode in the electrostatic spray gun nozzle applies an electric charge to the spray, causing a naturally occurring magnetic force between the spray droplets and targeted surface. While the charge on the droplets is small, the force pulling the spray toward the target is up to 75 times greater than the force of gravity. During activation, the droplets reverse direction and move upward against gravity. Hard-to-reach undersides, backsides and nooks of any surface are reached, creating a 360-degree clean with our proprietary AirBiotic products to restore normal fungal ecology in your property.
Other hard to reach areas include attic and crawlspace beams.

Mold can leave an unpleasant odor in the air even after removal. A hydroxyl generator and maximizer are innovative tools to refresh the air, remove odors and kill germs.
A hydroxyl generator harnesses existing water vapor in the atmosphere to create hydroxyl radicals. The maximizer is placed behind the generator to increase the direct intake of humidity, which increases the hydroxyl production. Humidity levels will not increase; instead there should be a 15 to 40 percent decrease as water molecules are processed and transformed into hydroxyl radicals.
No ozone is produced during the process, making it 100 percent safe to run in areas where your family or workers are.
The Environmental Protection Agency (EPA) has yet to set federal limits on mold and mold spores to check a building’s compliance with federal mold standards. The EPA has issued a decree in which sampling is unnecessary when visible mold growth is present. However, surface sampling may be useful to determine if an area has been adequately cleaned or remediated.
Miami Mold Specialist has decades of experience designing mold sampling protocols and methods, and interpreting results. Our technicians follow the analytical methods recommended by the American Industrial Hygiene Association (AIHA), the American Conference of Government Industrial Hygienists (ACGIH), or other professional organizations.
If visual evidence of mold cannot be detected, an air sample can be taken to check if mold is present in a specific open area or surface. A sampling can detect the probability of contamination via elevated moisture, an increased humidity level and the presence of condensation.
All samplings are sent to a third-party laboratory for examination to determine the type of mold present and the mold spore count in the tested area(s). Results typically take one to two business days to be received and include common health symptoms related to the type(s) of mold found.

An attic can be the perfect breeding ground for mold growth. Solar Air Flow removes excess heat and moisture, keeping insulation intact. Solar Air Flow saves you money and provides your home with normal fungal ecology. Your shingles are directly impacted by the Florida sun every day, absorbing heat and distributing it directly to your attic. Solar Air Flow allows your shingles to stay cooler and last longer with the maintenance of the desired home temperature.

An ozone machine is used to kill living mold spores and is one of the most effective air purifiers. This machine prevents the spores from spreading.

Miami Mold Specialist now offers a fully organic product line crafted for our Signature Mold Remediation Process. We pride ourselves on being the only mold service company offering clients a fully organic and bio-degradable remediation package to ensure that no toxins or volatile organic compounds are released into the air.
Our Penetrating Coil Cleaner has no volatile organic compounds and is exclusively made to be used on A/C unit coils for disinfecting, cleaning and mold prevention. The Super Primer encapsulates and seals any type of mold contamination on ductwork, and can also be used on small areas of walls/ceilings. This aluminum colored product is an antimicrobial disinfectant used on A/C units and can also be used as an anti-fungal coater. In addition to these items, we have two products coming soon: the All Purpose Cleaner and the Penetrating Deep Cleaner.

Each technical crew at Miami Mold Specialist is fully equipped with Wi-Fi-integrated equipment in order to provide real time updates and results to the office staff. All of our technicians use a body camera or camera-integrated glasses to film the entire assessment and/or treatment from start to finish in order to record data, ensuring accuracy and quality.
There is always a state certified environmentalist overlooking the job site from our office. After the service is completed, the footage will be reviewed by the on-site manager to verify that all findings were correctly documented in the report and to prevent loss of important information.

Our team at Miami Mold Specialist is always looking for innovative ways to help our clients achieve clean air quality and a healthier living environment. With the help of our friends at AirBiotics, we offer our customers an eco-friendly cleaning product to that contains no volatile organic compounds, is pet-friendly, and inhibits allergens. For most of our clients, allergies are a common symptom when exposed to mold. Mold exposure can be extremely detrimental toward your health in the short- and long-term. It is our pleasure to introduce the AirBiotics All Natural All Purpose Cleaning Kit, which will soon be provided to all of our clients as a post-remediation gift. Our goal is to ensure that after remediation is completed, our clients have an all-in-one product that can be used to clean any surface and will allow them to keep their property’s fungal ecology at an appropriate level.











